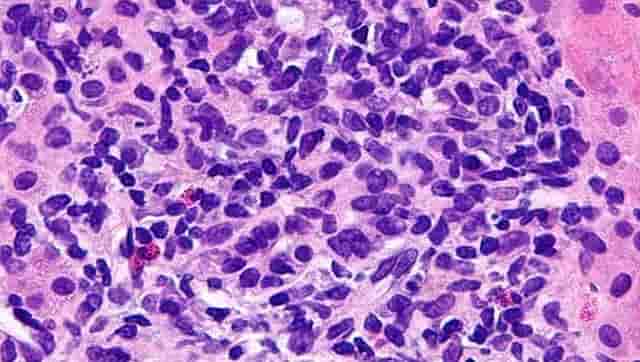
World Hepatitis day 2020: Awareness key to prevent liver disease; B and C variants most common causes of death World Hepatitis day 2020: Awareness key to prevent liver disease; B and C variants most common causes of death

World Hepatitis Day is observed every year on 28 July to increase awareness of viral hepatitis, an inflammation of the liver that causes a number of health ailments including liver cancer. As per the World Health Organisation (WHO), there are five main strains of the hepatitis virus – A, B, C, D and E. Together, hepatitis B and C are the most common cause of death. The health organisation says that 325 million people are living with viral hepatitis B and C. Every year 9 lakh deaths are caused by hepatitis B virus infection. The theme for World Hepatitis Day 2020 is ‘Hepatitis-free future’. The main focus is on preventing hepatitis B among mothers and newborns. The date 28 July was chosen to observe the day as it is the birthday of Nobel-prize winning scientist Dr Baruch Blumberg who discovered hepatitis B virus (HBV). Blumberg also developed a diagnostic test and vaccine for the virus. According to a report by Hindustan Times, symptoms of hepatitis are hard to detect people may not show as any signs or can also be confused with the common flu. If a person sees signs of fatigue, muscle pain, fever, loss of appetite, light-coloured stools, nausea and vomiting, then he/she should see a doctor at the earliest. Treatment at the right time can prevent the person from liver cirrhosis or scarring which may lead to liver cancer. There is no vaccination for hepatitis apart from hepatitis A and B. Other strains of this disease can be prevented by taking precautions including avoiding consumption of raw food, unfiltered water. A person should also not share his/her toothbrushes, razors or any hygiene-related products with others. Also, it is advised to use condoms and dental dams for safe sex. The Union Minister of Health and Family Welfare tweeted a video describing the probable causes of hepatitis and how a person can prevent himself/herself from it.
#WorldHepatitisDay2020
— Dr Harsh Vardhan (@drharshvardhan) July 28, 2020
⏺️हेपेटाइटिस वायरस से बचने में हुई चूक तो बन सकता है ये जानलेवा !
⏺️#Hepatitis का ख़तरा किसी को कभी भी हो सकता है।
⏺️इससे बचाव के उपायों और लक्षणों के बारे में जानकर आप इस बीमारी से बच सकते हैं।@MoHFW_INDIA @NHPINDIA pic.twitter.com/jL6FvHT8Op
Union Minister Sadananda Gowda said on World Hepatitis Day 2020, people should take a pledge to raise awareness of hepatitis, encourage prevention, diagnosis and treatment and support Hepatitis Patients.
On this #WorldHepatitisDay, let us pledge
— Sadananda Gowda (@DVSadanandGowda) July 28, 2020
to raise awareness of hepatitis, encourage prevention, diagnosis & treatment and support Hepatitis Patients. pic.twitter.com/75cPBblNDC
Union Minister Dharmendra Pradhan said that even though hepatitis is preventable and curable, millions of people are living with the disease globally. He urged for timely testing and vaccination to build a “Hepatitis-free” future.
Hepatitis is preventable and curable, yet we have millions living with this disease globally. This #WorldHepatitisDay, let us pledge to raise awareness on prevention, timely testing and vaccination to build a "Hepatitis-free" future. pic.twitter.com/Ss04xauNUI
— Dharmendra Pradhan (@dpradhanbjp) July 28, 2020
Odisha chief minister Naveen Patnaik said that people should pledge to raise awareness and further scale up access to treatment to realise the global goal of Hepatitis Free Future."
Millions of people are unaware that they are living with preventable and treatable #Hepatitis. On #WorldHepatitisDay, pledge to raise awareness and further scale up access to treatment to realise the global goal of #HepatitisFreeFuture. pic.twitter.com/nn1oLdcBLJ
— Naveen Patnaik (@Naveen_Odisha) July 28, 2020
Tripura chief minister Biplab Kumar Deb urged people to spread awareness for Hepatitis-free future and said, “With the lack of awareness, millions of people across the globe are losing their lives to this deadly infection.”
#WorldHepatitisDay is observed every year on 28th July to spread awareness on Hepatitis.
— Biplab Kumar Deb (@BjpBiplab) July 28, 2020
With the lack of awareness, millions of people across the globe are losing their lives to this deadly infection.
Let's spread awareness for “Hepatitis-free future”. pic.twitter.com/oWVosFQDFL

)

)
)
)
)
)
)
)
)
